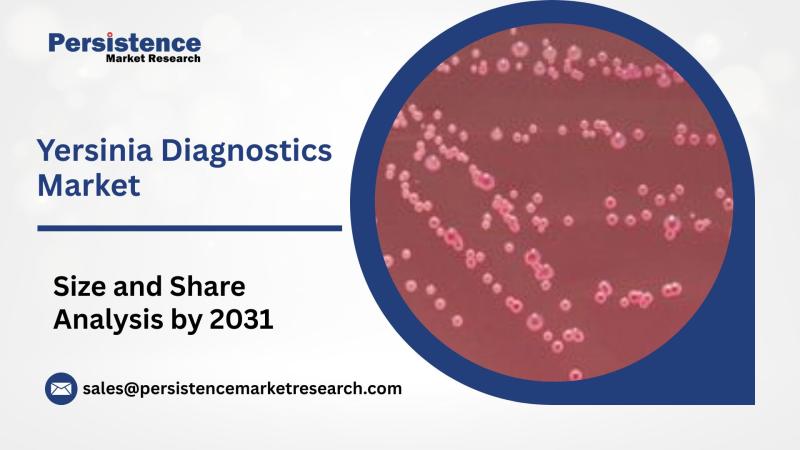

Press release
Petroleum Coke Market Players British Petroleum, Marathon Petroleum Corporation
Introduction:Petroleum coke or petcoke, a solid rock material is a byproduct of crude oil refining and other cracking processes. Although a refining byproduct, petroleum coke is considered as a valued commodity since 2008, all over the world. Crude oil remained after separating other valuable petroleum products from refining process such as diesel, lubricants, waxes, etc. can be processed further in cokers or other cracking processes to produce petroleum coke. Different grades of petroleum coke are produced by varying the coking operation temperature, coking time length, and quality of raw material used. The grades available are needle coke, purge coke, sponge coke, shot coke, and catalyst coke. The different grades differ in their physical properties and VOC (Volatile Organic Content). It is generally used as a source of energy in various industries due to its high calorific value, as compared to metallurgical coal and bituminous coal. About 80% of the petroleum coke produced is used as energy source in various industries. Cement kiln and power plants are the chief end users. Another prominent use of petroleum coke is in manufacturing of metal, where it is used to manufacture anodes for EAFs (Electric Arc Furnaces). The niche applications of petroleum coke includes production of titanium dioxide for paint and coloring industry, feedstock for coke oven batteries, to produce urea and ammonium nitrate for paper industry and fertilizer, etc. High sulphur, low grade petroleum coke (fuel grade) is generally used as a source of energy, while low sulphur, high grade petroleum coke is used for other uses by the manufacturers. Petroleum coke is a cost effective alternative to coal with higher calorific value, lower ash content.
Request Report Sample@ https://www.persistencemarketresearch.com/samples/11386
Global Petroleum Coke Market Dynamics
The production of the petroleum coke is linked with the production of oil, as it is a byproduct of oil refineries. The market is highly price sensitive and the global consumption of petroleum coke is highly dependent on competitive prices in fuel market. The global petroleum coke market is driven by increasing global energy demand. Petroleum coke being used as energy sources by power plants is highly influenced by increasing global energy demand. Growth of cement & construction industry is another driving factor for petroleum coke market growth. The advancement in technology that increased the oil production is also driving the market globally. EPA (environmental protection agency) has not classified petroleum coke as a hazardous material, eventhough it is found to be having adverse effects on aquatic and terrestrial environments due to higher level of sulphur content. Although there are no specific regulations for petroleum coke industries, the environmental regulations are the key restraints for the market. Furthermore the market is influenced by highly volatile fuel prices and is a key challenge for the market.
Global Petroleum Coke Market Segmentation
The global petroleum coke market is segmented on the basis of product type and end uses. On the basis of product type, the global petroleum coke market is classified as needle coke, sponge coke, catalyst coke, shot coke, and purge coke. On the basis of end use, the global petroleum coke market is segmented as power plants, cement industry, steel industry, Aluminum industry, others. The other end uses of petroleum coke includes bricks and glass, paints and coloring industries, etc. More than 80% of petroleum coke produced is used as a source of energy by the end users.
Global Petroleum Coke Market: Regional Outlook
Geographically, the Global petroleum coke market can be divided by major regions which include North America, Latin America, Western and Eastern Europe, Asia-Pacific region, Japan, Middle East and Africa. U.S. is a key exporter of petroleum coke. It exports more than 80% of the petroleum coke produced in the region. China, India, Japan, Mexico, and Turkey are the key export market for U.S. Apart from U.S., Canada, Spain, Germany, China are the major exporting countries.
Visit For TOC@https://www.persistencemarketresearch.com/toc/11386
Global Petroleum Coke Market Players
About 140 refineries produce petroleum coke all over the world. Some of the major petroleum coke manufacturing companies are ExxonMobil, Chevron, Valero, British Petroleum, Marathon Petroleum Corporation, etc.
About Us
Persistence Market Research (PMR) is a third-platform research firm. Our research model is a unique collaboration of data analytics and market research methodology to help businesses achieve optimal performance.
To support companies in overcoming complex business challenges, we follow a multi-disciplinary approach. At PMR, we unite various data streams from multi-dimensional sources. By deploying real-time data collection, big data, and customer experience analytics, we deliver business intelligence for organizations of all sizes.
Contact Us
Persistence Market Research
305 Broadway
7th Floor, New York City,
NY 10007, United States,
Telephone - +1-646-568-7751
USA – Canada Toll Free: 800-961-0353
Email: sales@persistencemarketresearch.com
Web: http://www.persistencemarketresearch.com
This release was published on openPR.
Permanent link to this press release:
Copy
Please set a link in the press area of your homepage to this press release on openPR. openPR disclaims liability for any content contained in this release.
You can edit or delete your press release Petroleum Coke Market Players British Petroleum, Marathon Petroleum Corporation here
News-ID: 1491368 • Views: …
More Releases from Persistence Market Research

Railway HVAC System Market to Reach US$ 9.7 Bn by 2032, Exhibiting a 4.1% CAGR
The railway HVAC system market plays a crucial role in ensuring passenger comfort, operational efficiency, and safety across modern rail networks. These systems regulate temperature, humidity, and air quality inside trains, contributing to a more pleasant travel experience while maintaining energy efficiency and compliance with environmental standards. With the growing demand for high-speed rail, metro expansion projects, and increased focus on passenger well-being, advanced HVAC systems are becoming indispensable in…

Booklet Label Market Size, Share, and Forecast 2024 to 2031: Projected Growth fr …
The global packaging and labeling industry has witnessed remarkable innovations in recent years, and booklet labels have emerged as a key solution for brands looking to provide extensive product information without compromising packaging aesthetics. Booklet labels, often referred to as multi-layer or extended content labels, offer an efficient way to communicate detailed information on a small surface area. These labels are especially valuable for industries such as pharmaceuticals, food and…
Yersinia Diagnostics Market to Reach US$467.0 Mn by 2031, Expanding at 6.3% CAGR
The Yersinia diagnostics market plays a crucial role in the detection and management of infections caused by Yersinia enterocolitica and Yersinia pestis, which are responsible for gastrointestinal and zoonotic diseases in humans. These diagnostic tests are essential for ensuring food safety, clinical diagnosis, and outbreak surveillance across healthcare and veterinary sectors. According to the latest study by Persistence Market Research, the global Yersinia diagnostics market is projected to grow from…

Hydrogen Electrolyzer Market Size to Reach US$53.3 Billion by 2032, Growing at a …
The global energy landscape is undergoing a transformative shift, driven by the urgent need to reduce carbon emissions and transition towards sustainable energy sources. Hydrogen, as a clean and versatile energy carrier, has emerged as a cornerstone in this transformation. Electrolyzers, which produce hydrogen from water through electrolysis, are at the heart of this transition.
The hydrogen electrolyzer market has gained significant momentum due to technological advancements, policy support, and…
More Releases for Petroleum
Green Petroleum Coke and Calcined Petroleum Coke Market : An Overview
Introduction:
Green petroleum coke (GPC) and calcined petroleum coke (CPC) are key by-products of the oil refining process. GPC, a carbon-rich material, is used primarily as a fuel in industries such as power generation and cement manufacturing. When subjected to high temperatures, GPC is transformed into CPC, which finds applications in aluminum smelting, steel manufacturing, and titanium dioxide production. Both materials are critical in various industrial processes due to their high…
Green Petroleum Coke and Calcined Petroleum Coke Market : An Overview
Introduction:
The green petroleum coke (GPC) and calcined petroleum coke (CPC) market is a critical segment of the global energy and materials industries. Green petroleum coke, a byproduct of crude oil refining, is an unprocessed carbon material used in various industrial applications. Calcined petroleum coke, produced by heating GPC at high temperatures, is primarily used in aluminum smelting, steel manufacturing, and chemical processes. With increasing demand for energy and industrial materials,…
Petroleum Jelly Petroleum Jelly Market Innovative Strategy by 2031 | Major Giant …
Petroleum Jelly Market: Introduction
Transparency Market Research delivers key insights on the global petroleum jelly market. In terms of value, the global petroleum jelly market is expected to expand at a CAGR of 4.26% during the forecast period, owing to numerous factors regarding which TMR offers thorough insights and forecasts in its report on the global petroleum jelly market.
Get a Sample Copy of the Report: https://www.transparencymarketresearch.com/sample/sample.php?flag=S&rep_id=72726
Petroleum jelly is used in the…
Global Liquefied Petroleum Gas Market 2020 Business Strategies – Chevron Corpo …
The market report titled “Liquefied Petroleum Gas Market By Source (Refinery, Associated Gas, and Non-Associated Gas) and By End-User (Residential & Commercial, Petrochemical & Refineries, Industrial, and Transportation): Global Industry Perspective, Comprehensive Analysis, and Forecast, 2018–2025” and published by Zion Market Research will put forth a systematizedevaluation of the vital facets of the global Liquefied Petroleum Gas Market market. The report willfunction as a medium for the better assessment of…
Natural Gas Market to Witness Huge Growth by 2025 | Qatar Petroleum, Sempra Ener …
The Global Natural Gas Market has witnessed continuous growth in the past few years and may grow further during the forecast period (2019-2025). The assessment provides a 360° view and insights, outlining the key outcomes of the industry, current scenario witnesses a slowdown and study aims to unique strategies followed by key players. These insights also help the business decision-makers to formulate better business plans and make informed decisions for…
Liquefied Petroleum Gas (LPG) Market Analysis By Key Players : British Petroleum …
Liquefied petroleum gas (LPG) is a flammable mixture of hydrocarbon gases that is used as fuel in heating appliances, vehicles, aerosol propellant, refrigerant and cooking equipment etc. In terms of cost and environmental benefits, LPG is way ahead of conventional fuels such as coal and wood. In fact, the gas is considered a revolutionary fuel solution for various sectors, such as industries, residential, chemical, automotive and refinery. This is why…